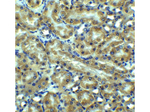
DR5 Antibody in Immunohistochemistry (Paraffin) (IHC (P))

Search
Rockland
DR5 Polyclonal Antibody
{{$productOrderCtrl.translations['antibody.pdp.commerceCard.promotion.promotions']}}
{{$productOrderCtrl.translations['antibody.pdp.commerceCard.promotion.viewpromo']}}
{{$productOrderCtrl.translations['antibody.pdp.commerceCard.promotion.promocode']}}: {{promo.promoCode}} {{promo.promoTitle}} {{promo.promoDescription}}. {{$productOrderCtrl.translations['antibody.pdp.commerceCard.promotion.learnmore']}}
产品信息
600-401-G96
种属反应
宿主/亚型
分类
类型
抗原
偶联物
形式
浓度
规格
纯化类型
保存液
内含物
保存条件
运输条件
靶标信息
DR5 (Apo2, TRAIL-R2, TRICK2, KILLER) is a recently identified death domain containing receptor for TRAIL, which mediates TRAIL induced apoptosis. DR5 is a member of the TNF-receptor superfamily, and contains an intracellular death domain. DR5 can be activated by tumor necrosis factor-related apoptosis inducing ligand (TNFSF10/TRAIL/APO-2L), and transduces an apoptosis signal. Studies with FADD-deficient mice suggested that FADD, a death domain containing adaptor protein, is required for the apoptosis mediated by DR5. Two transcript variants encoding different isoforms of DR5 and one non-coding transcript have been found. Overexpression of DR5 induces apoptosis and activates NF-kappa-B. DR5 is expressed in a number of cell types, and to particularly high levels in lymphocytes and spleen. Diseases associated with DR5 dysfunction include squamous cell carcinoma, and diffuse infiltrative lymphocytosis syndrome.
仅用于科研。不用于诊断过程。未经明确授权不得转售。
篇参考文献 (0)
生物信息学
蛋白别名: apoptosis inducing protein TRICK2A/2B; apoptosis inducing receptor TRAIL-R2; CD262; cytotoxic TRAIL receptor-2; death domain containing receptor for TRAIL/Apo-2L; Death receptor 5; dr-5; DR4 homolog; Fas-like protein; KILLER/DR5 TRAIL death-inducing receptor; MK; p53-regulated DNA damage-inducible cell death receptor(killer); sCD262; second apoptosis inducing receptor for TRAIL; apoptosis-mediating receptor for TRAIL; soluble CD262; TNF-related apoptosis-inducing ligand receptor 2; TNFR family member; TNFRSF10B; TRAIL receptor 2; Tumor necrosis factor receptor superfamily member 10B; tumor necrosis factor receptor superfamily, member 10b; tumor necrosis factor receptor-like protein ZTNFR9; unnamed protein product
基因别名: CD262; DR5; KILLER; KILLER/DR5; Ly98; MK; TNFRSF10B; TRAIL-R2; TRAILR2; TRICK2; TRICK2A; TRICK2B; TRICKB; UNQ160/PRO186; ZTNFR9
UniProt ID: (Human) O14763, (Mouse) Q9QZM4
Entrez Gene ID: (Human) 8795, (Mouse) 21933, (Rat) 364420